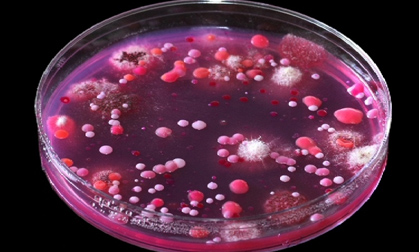

Danh mục

17.08.2022

09.02.2018

13.09.2017

14.05.2017

28.03.2017
29.12.2016

14.12.2016

13.11.2016

19.02.2016

16.11.2015

15.03.2015

02.12.2014